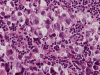
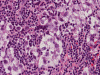

T1+Contrast
CT+Contrast
Frozen
Frozen
Frozen



| A 49 year-old Man with
Headache and a Pineal Mass. January, 2009, Case 901-1. |
Andrew Hong, B.S. (MS-IV)1, Kar-Ming Fung, M.D., Ph.D.2 Last update: April 10, 2009.
1 Fourth year medical student, Class of 2010, College of Medicine, University of Oklahoma, 2 Department of Pathology, University of Oklahoma Health Sciences Center, Oklahoma City, Oklahoma.
Clinical information: This patient was a 24 year-old Caucasian male who presented to the Emergency Department with a 6 month history of blurry vision with occasional diplopia and problems with horizontal eye movements. Patient reports during the past 6 months he had also been experiencing increasingly severe headaches, fatigue, an unintentional loss of 70 lb in weight, decreased hearing bilaterally, and increased urination and thirst. Patient reported no significant past medical history. Family history was noncontributory. Patient stated prior heavy alcohol use of 1 year duration, an eight pack year smoking history, and use of methamphetamine and cocaine. Physical exam revealed an overall slowness in mentation and movements. Neurologic exam revealed paralysis of vertical gaze, loss of accommodation and a positive Romberg. Abnormal laboratory values found included decreased luthenizing hormone (LH) of less than 0.1, decreased follicle stimulating hormone (FSH) of 0.45, and elevated prolactin of 34.48. The carcinoembryonic antigen (CEA) level in serum was 1.15 ng/mL, alpha fetal protein (AFP) less than 0.5 ng/mL and elevated human chorionic gonadotropin (HCG) at 145.9. Both CT scan and MRI were performed and an endoscopic biopsy was performed. The followings are representative images form the imaging studies and pathologic specimen from the pineal gland.

|

|
 |
 |
 |
 |
|
A. T1+Contrast |
B. CT+Contrast |
C. Frozen |
D. Frozen |
E. Frozen |
F. |
|
|
 |
|||
| G. | H. | Scanned slide |
Imaging of the Case: MRI demonstrated a 4.4 x 3.5 x 4.7 cm mass in the pineal region. The lesion is isointense on T1 with homogeneous post contrast enhancement (Panel A) and slightly hyperintense on T2. The tumor is relatively well demarcated. The tectal plate is not visualized and mass effect is demonstrated upon the third ventricle outflow tract and midbrain. A second but smaller lesion of similar imaging characteristic is dmonstrated in the suprasellar region involving the optic chiasma. There is also mild hydrocephalus. CT scan (Panel B) demonstrated also a similar enhancing lesion. Calcifications are demonstrated on both MRI and CT scan.
Pathology of the Case: The sample submitted for frozen section has a papillary structure which can be identified as the choroid plexus (Panel C). The center of the choroid plexus is expanded by some large cells accompanied by some smaller cells presumably lymphocytes (Panel D and E). On hematoxylin and eosin stain of the permanent sections, the tumor is composed of clusters of large cells in a background of lymphocytes. On higher magnification, the large cells have enlarged nuclei with prominent nucleoli. No trophoblasts or nor seminomatous component are identified. Immunohistochemistry demonstrated strong positive reactivity for placental alkaline phosphatase (PLAP) (Panel I) and CD117 (c-kit) in the large atypical cells (Panel J). The lymphocytes in the background are strongly immunoreactive for leukocyte common antigen (LCA) (Panel K) but negative for PLAP and CD117.
| DIAGNOSIS: Germinoma. |
Discussion:
General Information
Primary intracranial germ cell tumors are uncommon tumors that are usually found in the pediatric population. They account for approximately 3% of primary pediatric brain tumors and are commonly found in the pineal and suprasellar regions of the brain 1. The incidence also varies by geographic regions, with a higher incidence found in Japan and Korea 2.
There are several different types of germ cell tumors, each with a different frequency of occurrence. Germinomas are the most common, accounting for 65% of cases, followed by teratomas at 18%, endodermal sinus tumors at 7%, embryonal carcinomas at 5%, and choriocarcinomas at 5% 3. Regardless of type, a male predilection is seen with one series demonstrating an 11:1 male to female ratio. As with most intracranial neoplasms, the clinical presentation depends on the size of the mass, location and associated structures affected. Pineal masses can cause obstructive hydrocephalus leading to nausea, headache, vomiting and lethargy. Pineal masses also commonly present with Parinaud’s syndrome, a triad consisting of the following symptoms: vertical gaze paralysis, dissociation of light and accommodation, and loss of convergence, due to compression of the tectum. Suprasellar masses can lead to disturbances in vision, such as bitemporal hemianopsia, various forms of pituitary endocrine abnormalities, such as elevated prolactin, and diabetes insipidus.
Embryology and Pathogenesis
Intracranial germ cell tumors are thought to arise from abnormal migration and subsequent neoplastic transformation of primordial germ cells 5. Primordial germ cells are first visible during the fourth week of gestation. They are initially found in the yolk sac. By the sixth week, they have migrated from the yolk sac, to the gonadal ridge by way of the dorsal mesentery of the hindgut. Then during the sixth week, the primordial germ cells become part of the primary sex cords. Germ cell tumors arising outside the gonads are believed to arise from residual germ cells along this migration pathway. As these cell migrate along the midline, most of the extragonadal germ cell tumors arise along the midline. As these cells are totipotent, they can have seminomatous differentiation which mimics the germ cells, with extra-embryonal differentiation (yolk sac tumor, choriocarcinoma, and embryonal cell carcinoma) and with embryonic differentiation (mature teratoma, immature teratoma). Teratomas can undergo malignant transformation to become malignant teratoma (teratoma with a malignant componet). In the central nervous system, the majority of them are geminomas with the pineal and sellar/suprasellar region as the most common and second most common location.
In this particularly case, the sellar/suprasellar tumor is not biopsied. The most likely clinical scenario is that the pituitary lesion is a local dissemination of the pineal germinoma. There is no evidence in this case that argue against simultaneous development of germ cell tumor in pineal and pituitary.
Typical diagnostic workups should include a CSF study for the tumor markers human chorionic gonadotropin (β-HCG) and alpha fetoprotein(AFP), but in most cases stereotactic biopsy is needed for diagnosis 5. Endoscopic biopsy typically yield a minute specimen which may not be representative of the tumor. With this token, the biopsy specimen may appear purely seminomatous but non-seminomatous component may be present in the tumor but not represented in the biopsy specimen. Serum markers help to detect these tumors. Markedly elevated levels of β-HCG usually indicate the presence of choriocarcinoma, while elevated levels of AFP indicate an endodermal sinus tumor. Mildly elevated levels of β-HCG are less specific, and could be seen in all types except teratomas. These serum markers are also helpful in the detection of tumor recurrence.
Pathology
The discussion here will be limited predominantly to germinoma. Histologically, germinoma has very characteristic features heralded by large, atypical germinoma cells in a background of benign lymphocytes. The germinoma cells are usually huge, with a moderated amount of cytoplasm, and with prominent nucleoli. These cells, even though large, are rarely bizarre. The proportion of germinoma cells with lymphocytes can be highly variable. While most cases show a good mix of both component, the small biopsies yielded by endoscopic biopsy can sample in areas that are lymphocyte predominant or germinoma cell predominant areas which lead to diagnostic pitfalls. It should also be reminded that germinoma has a strong tendency to undergo granulomatous changes. Such granulomatous changes may completely efface the usually big cell-small lymphocyte classic pattern. These biopsies, however, would histologically suggest infection but the clinical history usually would not. Knowing the clinical history is often helpful. Trophoblastic cells could be seen and their presence may indicate a worse prognosis for germinomas. Non-seminomatous component such as embryonal cell carcinoma, yolk sac tumor (endodermal sinus tumor), and choriocarcinoma should also be identified if present.
The germinoma cells are positive for several immunohistochemical markers. These adjuncts are helpful for confirming the diagnosis or when the tumor is composed largely of the large, atypical germinoma cells. The germinoma cells are positive for placental alkaline phosphatase (PLAP) and OCT4 6. They are also positive for CD117 (c-kit) but it should be noted that CD117 is not as specific as PLAP or OCT4.
Differential Diagnosis
Prognosis
The type of intracranial germ cell tumor is a major determinant of prognosis and treatment strategy, so the elucidation of the exact type is of great importance. In the brain, germinomas have the best overall prognosis, with one series showing three year event free survival of around 98% following combination chemotherapy and radiation treatment 7. Teratomas have a fairly good survival rate depending on type, ranging from 70.7% to 92.9% 8. Embryonal carcinoma, yolk sac tumor (endodermal sinus tumor) and choriocarcinoma types have a much less favorable prognosis, with three year survival rate of 27.3% 7.
Reference:
Echevarria ME, Fangusaro J, Goldman S. Pediatric central nervous system germ cell tumors: a review. Oncologist 2008 Jun; 13(6): 690-9.
Knierim DS, Yamada S. Pineal tumors and associated lesions: the effect of ethnicity on tumor type and treatment. Pediatric Neurosurgery 2003 Jun;38(6):307-23.
Jennings MT; Gelman R; Hochberg F. Intracranial germ-cell tumors: natural history and pathogenesis. Journal of Neurosurgery 1985 Aug;63(2):155-67.
Oosterhuis JW, Stoop H, Honecker F, Looijenga LH. Why human extragonadal germ cell tumours occur in the midline of the body: old concepts, new perspectives. International Journal of Andrology 2007 Aug;30(4):256-63.
Packer RJ, Cohen BH, Cooney K. Cooney K. Intracranial germ cell tumors.[erratum appears in Oncologist 2000;5(5):following 438 Note: Coney, K Oncologist. 2000; 5:312-20.
Hattab EM, Tu PH, Wilson JD, Cheng L. OCT4 immunohistochemistry is superior to placental alkaline phosphatase (PLAP) in the diagnosis of central nervous system germinoma. American Journal of Surgical Pathology. 2005; 29:368-71.
Matsutani M, Sano K, Takakura K, Fujimaki T, Nakamura O, Funata N, Seto T. Primary intracranial germ cell tumors: a clinical analysis of 153 histologically verified cases. Journal of Neurosurgery. 1997; 86:446-55.
Bouffet E; Baranzelli MC; Patte C; Portas M; Edan C; Chastagner P; Mechinaud-Lacroix F; Kalifa C. Combined treatment modality for intracranial germinomas: results of a multicentre SFOP experience. British Journal of Cancer. 1999 Mar;79(7-8):1199-204.
Cases of the Month Evaluation Coordinator: KarMing-Fung@ouhsc.edu
Copyrights reserved.